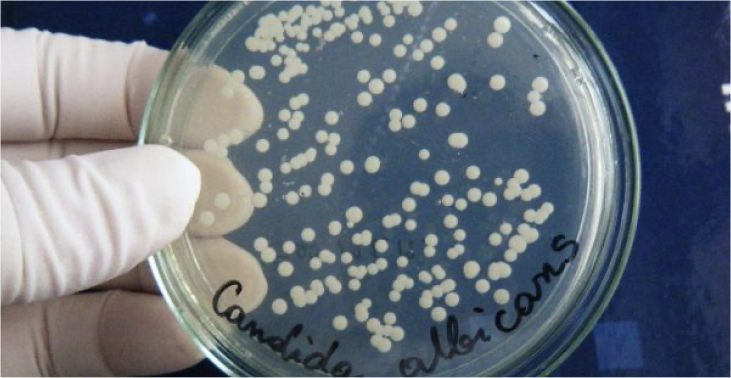

Необычные методики
Среди народных способов можно найти результативные необычные способы, которые приносят ощутимую пользу в борьбе с грибком ногтей на ногах и руках.
Окуривание дымом
При поражении нескольких ногтевых пластин берут хлопчатобумажную ткань. Сворачивает ее трубочкой длиной около 10 см, и выдерживают толщину примерно с указательный палец.
Необходимо поджечь один конец трубочки. Когда сгорит 4 сантиметра, следует пламя потушить, а дымом окурить пораженные участки. Уже после семи ежедневных сеансов утолщенные ногти начинают отпадать, и вырастают новые здоровые пластинки.
Лечение порохом
Понадобится бездымный порох. Его при аккуратном вымешивании соединяют со сметаной, чтобы получить массу, по консистенции напоминающую крем.
Выкладывают на участки, зараженные онихомикозом. Прикрывают пленкой, а затем завязывают бинтом. Оставляют такой компресс на трое суток.
«Доместос» от грибка
Оказывается, губительно воздействует на грибок чистящее средство типа «Доместос». Нужно небольшое его количество перелить в небольшую емкость
При помощи ватной палочки осторожно смазывают один раз за сутки инфицированную плоскость ноготка и дают время для высыхания
Можно выполнять ножные (или ручные) ванночки. Наливают в миску горячую воду и растворяют «Доместос», рассчитывая, что потребуется 1 ст. л. средства на 5 л жидкости. Продолжительность сеанса 25-30 минут. Проводят их через день.
Применение кофе
Если грибок развивается на ногтевых пластинках рук, благотворное воздействие оказывает кофе. Следует каждый вечер опускать пальцы в миску с заваренным горячим кофе, который перед процедурой не процеживают.
Оказывает такая методика пользу и при локализации инфекции на ногах, просто жидкости потребуется примерно три литра. Сеанс продолжается 15 минут.
Диагностика кандидоза
Основой для постановки диагноза являются жалобы пациента, данные осмотра. Для подтверждения диагноза доктор берет соскоб, затем в лаборатории производится посев полученного материла. Это также нужно для определения чувствительности гриба к конкретным препаратам.
Виды взятия материла: соскоб со слизистой оболочки, мазок-отпечаток, мазок-перепечаток, забор слюны, смывы из полости рта. Например, при видимых поражениях слизистой оболочки используют соскобы и мазки непосредственно с места поражения. В случаях, когда нет четкого элемента поражения или когда оно расположено в труднодоступном участке ротовой полости, возможно использование непрямых методик забора материала, например, слюны или получение смывов с слизистой оболочки полости рта.
Для микроскопического исследования пациенту за 3–4 дня до забора материала рекомендуется не использовать противомикробные средства местного или системного действия, анализ сдают натощак и до чистки зубов.
Как уже говорилось ранее, доктор ставит диагноз кандидоз на основании клинических данных, истории заболевания и, конечно же, результатов анализов.
Очень важно поставить верный диагноз, потому что симптомы кандидоза слизистой оболочки полости рта очень схожи с симптомами других заболеваний, например, с красным плоским лишаем. Поэтому важна дифференциальная диагностика
Березовый деготь и дегтярное мыло
Березовый деготь – продукт, получаемый путем сухой перегонки бересты. Его успешно используют в качестве антисептического и противовоспалительного средства. Лечение грибка ногтей березовым дегтем также эффективно, ведь он отлично размягчает ороговевшую кожу. Народные лекари предлагают смазывать кожу чистым березовым дегтем, а также наносить приготовленные на основе дегтя взбалтываемые смеси и мази.
Натуральный березовый деготь наносят на заранее обработанные ступни: их распаривают в мыльной ванночке (15 минут), после чего обрезают ногти, пораженные грибком, и снимают мертвую кожу со ступней. Межпальцевые зоны насухо вытирают, и ватной палочкой на пораженные участки наносят, слегка втирая в кожу, березовый деготь.
На протяжении 1.5 часа не стоит двигаться и во что-либо обуваться. Мазь должна впитаться в кожу при доступе воздуха. Затем на ноги надеваются носки из натуральных материалов. Через 2-3 дня ноги моют в холодной воде с мылом и вновь повторяют процедуру. Во время лечения можно обрабатывать березовым дегтем и стельки.
Лечение грибка ногтей дегтем возможно и посредством мази. Для ее приготовления следует взять любую жировую основу (детский крем, к примеру, или нутряной жир), и к ней добавлять деготь. В начале лечения его концентрация не должна превышать 5%. Впоследствии можно использовать до 15-20% дегтя.
Некоторые предпочитают использовать серно-дегтярную мазь. В ее составе 3 части дегтя, 2 части порошка серы и 10 частей жировой основы. Эти компоненты подогревают и смешивают до однородного состояния. Такую мазь накладывают на ноготь, а сверху кладут пластырь.
Удобнее всего пользоваться болтушкой. Состоит она из глицерина и дегтя, взятых по 50 мл, и 70 мл. спирта. Ингредиенты смешивают в темной посуде и смазывают пораженные ногти по несколько раз в день.
Около 10% березового дегтя содержится в дегтярном мыле. Да, оно неприятно пахнет, но зато кожа хорошо дезинфицируется и быстро восстанавливается. Вот лишь несколько вариантов использования дегтярного мыла.
Вариант 1. Ванночки для ног. Дегтярное мыло натереть на терке, отмерить 2 ст.л. Это количество довести до полного растворения в 2 литрах горячей воды, а затем опустить в раствор ноги на 15-20 минут.
Вариант 2. 1 ст.л. натертого мыла слегка разводят водой, добавляют 2 ч.л. пищевой соды и активно перемешивают. Получившуюся смесь втирают в пораженный ноготь. Делают это один раз в сутки при помощи жесткой щетки для зубов.
Вариант 3. Ногти тщательно намыливают дегтярным мылом, а поверх пены посыпают ногти пищевой солью. Пальцы и ступни обматывают бинтом из эстетических соображений. Утром бинт снимают, а ноги промывают теплой водой. Считается, что через неделю грибок должен отступить.
Видео:ГРИБОК СЛЕТАЕТ С НОГТЕЙ СРАЗУ! Домашний способ избавления. Грибок на ногах. Зелёная болтушка.Скачать

При поражении грибка ногтей и между пальцами ног
На начальной стадии заболевания, появляется не большой дискомфорт и зуд, по этому многие не обращают особого внимания на эти признаки. Игнорирование симптомов микоза, приводит к серьезным и неприятным последствиям, через какое то время заболевание начинает прогрессировать, ногти утолщаются и начинают слоиться, а потом и вовсе отпадают, кожа теряет свой естественный цвет.
Не стоит не до оценивать болезнь и при появлении первых симптомов микоза- стоит сходить в больницу.
Начальная стадия грибка, между пальцев ног.
Увеличивается риск грибкового заболевания во время, приема антибиотиков и при болезни сахарным диабетом. Если вовремя обнаружить заболевание — лечение будет легким. Но все же, нужно быть готовым к тому, что лечение проходит длительный период времени, вылечиться от грибка можно будет месяц или тогда, когда грибковая инфекция полностью уничтожится и кровь очистится от микроорганизмов. Но если болезнь грибка перейдет с кожи на ногти, излечиться от грибка можно будет только через двенадцать месяцев.
Причины появления микоза:
- авитаминоз;
- беременность;
- нарушение обменных процессов в организме;
- варикоз на ногах;
- сахарный диабет;
- выраженная потливость ног;
- пожилой возраст;
Существует два основных вида заражения. Один из них — прямой, когда инфекция передается через контакт от человека или животного, а так — же через почву, или другую среду где, есть споры грибка. Второй, не прямой путь, возникает при передачи предметов быта.
- Постоянно влажная среда между пальцами ног;
- Посещение общественных мест с теплой и влажной средой (баня, сауна,бассейн);
- частые царапины и ранки на коже;
- не качественная обувь, из не натуральных материалов;
- нарушение гигиены;
Рецепты которые помогут вылечиться от микоза:
- Ванночка с яблочным уксусом против микоза: опустить ноги в ванночку с 9% яблочным уксусом, налитым в ванночку в таком количестве, чтобы скрыть полностью стопу. Предварительно жидкость стоит подогреть и держать ступню в уксусе 15 минут.
- На литре теплой воды растворить 1 столовую ложку соли (лучше морскую). И парить ноги не менее 20 минут, потом насухо вытереть ноги и одеть теплые носки. Лучше всего делать это перед сном.
- Отварить картофельную кожуру, сваренную кожуру вытащить, а в оставшуюся жидкость опустить ноги на 25 — 30 минут. Для дополнительного эффекта нужно потереть между пальцами ног кожурой, после этого насухо вытереть ноги и намазать свиным жиром, для защиты стопы одеть теплые носки.
Профилактика повторного заражения
Споры патогенных грибков устойчивы к внешним факторам, поэтому заболевание склонно к рецидиву
Чтобы избежать повторного заражения, нужно соблюдать простые меры предосторожности:
- личная гигиена (нужно регулярно принимать ванну или душ, мыть ноги желательно с дегтярным мылом);
- ношение обуви в общественных банях, бассейнах и т.п;
- здоровое питание (в пищу нужно употреблять больше фруктов и овощей, особенно чеснока и лука);
- своевременное лечение любых инфекционных заболеваний (рецидив онихомикоза часто происходит на фоне других болезней).
После излечения необходимо приобрести новую обувь, в старой могут сохраняться грибковые споры. Также рекомендуется постирать постельное белье в горячей воде, отдать в чистку ковры.
Повторять процедуры с народными средствами нужно еще некоторое время, желательно 2-3 раза в неделю, чтобы закрепить эффект.
Врачи не выступают против применения домашних рецептов для лечения и профилактики, но настаивают на комплексной терапии. Она включает также прием противогрибковых средств внутрь.
Домашние средства
К домашним народным средствам против грибка ногтей на ногах относится применение различных продуктов, которые находятся под рукой у каждого человека. Популярностью в лечении микоза пользуются сода, соль, уксус.

Популярные средства от грибка ногтей
Существует несколько народных рецептов от грибка ногтей на ногах на основе соды. По отзывам людей самыми эффективными считаются следующие из них:
- Содовая паста. Она готовится легко. Требуется добавлять постепенно в продукт теплую воду, пока не получится своеобразная кашица. Паста наносится на пораженную стопу, ногти ноги на 10 минут, после смывается водой. Средство помогает устранить зуд, противостоять развитию инфекции. Специалисты рекомендуют для эффективности проводить процедуру утром и вечером.
- Ванночки с содой, когда требуется хорошо распарить ноги. После 30 минутной процедуры следует тщательно просушить ноги, обернуть их в подготовленные носочки, в которые можно насыпать специальную присыпку против потливости ног и микоза. В комплексе при ежедневном применении метод позволит отрастить новый здоровый ноготь на ноге, поэтому терапия продолжается до полного исцеления.
Соль применяется чаще всего в качестве обертывания. Требуется тщательно распарить ноги, обернуть их в подготовленную соль. Процедура должна длиться не более 10 минут. После ноги хорошо промываются и просушиваются.
Как вылечить грибок ногтей на ногах народными средствами на основе уксуса подскажут следующие рецепты.
Военный способ избавления от грибка ногтей ног – раствор уксуса 9%. Он разводится с водой в пропорции 1:1. Средство используется в качестве компресса. Лечение проводится так: раствор наносится на ватный диск, прикрепляется к пораженному участку, покрывается целлофаном. Необходимо надеть сверху теплые носки. Применяется метод на ночь, утром следует промыть ноги дегтярным мылом и одеть чистые носки. Средний курс – 2 недели.
- Йод и яблочный уксус – лучшее народной средство, помогающее избавиться от самой запущенной формы микоза. Лечение проходит на протяжении 2-3 недель. Средства смешивают в пропорции 1:1, наносят на ногтевую пластину каждый день, пока не отрастет здоровый ноготь.
Народные рецепты с чесноком от грибка ногтей
Чеснок от грибка ногтей на ногах можно применять самыми разными способами. Он одинаково эффективен как в свежем виде, так и в форме настоев, настоек и отваров. Его можно использовать целиком, либо выжимать из него сок или измельчать до состояния кашицы.
Кроме того, известны способы значительно усилить лекарственные свойства чеснока. Для этого к нему рекомендуется добавить другие лечебные компоненты, такие как репчатый лук, морская соль, лимон, уксусную кислота, сливочное или растительное масло.
Несмотря на свою простоту народные рецепты с чесноком помогают быстро справиться с грибком ногтей и навсегда забыть о данном неприятном заболевании. Их эффективность проверена сотнями лет успешного применения и тысячами выздоровевших пациентов.
Чесночная настойка
Ингредиенты:
- Чеснок – 1 головка,
- Медицинский спирт – 50 мл.
Головку чеснока очистить от шелухи, разделить на зубчики и снять с них кожуру. Чеснок мелко порезать или пропустить через пресс. Полученную чесночную массу сложить в стеклянную баночку, залить спиртом и поставить настаиваться в темное прохладное место на 3 дня.
Готовой настойкой смочить ватный диск и тщательно обрабатывать пораженный ноготь дважды в день. Также можно сделать лечебный компресс, смочив в настойке марлевый тампон, приложив его к больному ногтю и обмотав пищевой пленкой. Поверх компресса следует надеть теплый носок и оставить от 40 минут до 1 часа.
Чесночное масло
Ингредиенты:
- Чеснок – 1 крупная головка,
- Масло (растительное или топленое сливочное) – 50 мл.
Очищенный чеснок пропустить через пресс или натереть на мелкой терке. Чесночную кашицу и выделившийся сок поместить в стеклянную банку, залить маслом и настаивать в темном прохладном месте 1 неделю. Полученным маслом смазывать грибковый ноготь 2 раза в день сочетая с вечерними компрессами.
Чесночный уксус
Ингредиенты:
- Чеснок – 1 головка,
- Уксус яблочный (можно заменить соком лимона) – 1 стакан.
Головку чеснока измельчить, переложить в стеклянную тару с крышкой и залить уксусной кислотой. Настаивать в прохладном защищённом от света месте 10 дней. В готовом настое смочить ватный диск и хорошо обработать инфицированный ноготь. Повторять процедуру не реже двух раз в день, а лучше сочетать с компрессами перед сном.
Луково-чесночный сок
Ингредиенты:
- Чеснок – 4-5 зубчиков,
- Лук – ¼ луковицы.
Лук и чеснок натереть на мелкой терке, переложить в сложенную в два слоя марлевую ткань и сдавив руками выжить луково-чесночный сок. Смочить в нем ватный диск или ватную палочку и тщательно протереть больной ноготь. Этот рецепт подойдет тем больным, которые не знают как лечить грибок соком чеснока и лука, но считают такое сочетание самым эффективным.
Чтобы усилить терапевтический эффект от вышеприведённых рецептов рекомендуется правильно подготовить ногтевую пластину к лечебной процедуре. Для этого необходимо распарить больную конечность в ножной ванночке с добавлением 2 ст. ложек морской соли, 0,5 ст. ложки соды и 3-4 капель йодной настойки.
Чеснок для лечения грибка стопы можно использовать и в свежем виде. Для этого один зубчик чеснока необходимо пропустить через пресс и покрыть полученной кашицей пораженную ногтевую пластину. Сверху компресс нужно укрыть пищевой пленкой, надеть плотный носок и оставить примерно на 2 часа.
Но можно сделать еще проще, а именно очистить крупный зубчик чеснока от кожуры, разрезать пополам и отсечь острый конец, придав ему квадратную форму.
Лечение в домашних условиях

Никто не отменял поход в больницу и консультацию с доктором. Это основа лечения. Но каждый человек может преумножить результаты медикаментозного воздействия путем использования народных методов. Главное условие – врач должен знать о ваших манипуляциях и подкорректировать лечение с их учетом.
Перед тем, как наносится уксусная эссенция против грибка ногтей, проводится распаривание и спиливание верхнего слоя ногтя. После каждой процедуры обязательно дезинфицировать пилочку, в противном случае споры будут возвращаться и атаковать с новой силой. Снятый слой ногтя позволит лекарствам проникнуть вглубь и уничтожить больше бактерий.
Компрессы
Наносят их ежедневно на
6-8 часов на ватном диске или вате обмотанной бинтом и фиксируют на пораженном участке. После снятия пораженный участок не мыть.
- Обычный яблочный уксус нанести на кожу. Он убивает множество грибковых спор.
- 10 мг. яблочного уксуса соединить с 2 каплями йода.
Ванночки
Принцип действия ванночек –
разбавление действующих веществ в воде.
- Температура должна быть комнатной.
- Процедура длится столько, сколько остывает вода, то есть порядка 15 минут.
- Проводится 2 раза в день.
- По окончании ноги не мыть и не вытирать, дать высохнуть.
Вылечить грибок на ногах уксусной эссенцией можно принимая ванночки, где на 1 литр охлажденной кипяченой воды добавить 45 мл. эссенции.
Примочки
Их делают ежедневно и держат
до получаса. Наносят посредством ватного диска, закрепляют пищевой пленкой. А сверху надевают чистый носок или перчатку из натуральной ткани.
- Для процедуры подходит 9% уксус. В него окунают ватный диск и накладывают на пораженный участок.
- Для лучшего эффекта добавляют к 9% уксусу глицерин 1:1.
- Еще один рецепт примочки от грибка – равные части глицерина, медицинского спирта и уксусной эссенции.
Мази
Чтоб сделать мазь от грибка для ног и рук в
домашних условиях основой всех ингредиентов берут вазелин. Он поможет удержать раствор на пораженном месте максимально долго. При этом поверхность смягчается, что облегчает проникновение лекарственных средств внутрь структуры ногтя.
Мази наносят ватной палочкой, заматывают пищевой пленкой и оставляют на всю ночь. С утра снимают повязку и тщательно промывают кожу с мылом. Процедура так же проводится ежедневно. Уксусная эссенция и яйцо – мощное сочетание для лечения грибка на ногтях.
- Не сложно сделать мазь из уксусной эссенции и яйца от грибка.
– Обычное куриное яйцо тщательно вымывают и опускают в уксусную эссенцию.
– Через 3-4 дня скорлупа почти полностью растворяется и после удаления яичной пленки ингредиенты перемешиваются.
– Для получения более густой консистенции добавляют сливочное масло.
– Уксус с яйцом не только уничтожит колонны спор, но и защитит ноготь от чрезмерного влияния агрессивных компонентов лекарства. - Взять две части уксусной эссенции, 1 часть глицерина, 1 часть оливкового масла и 1 часть Диметилфталата.
– Эту смесь так же наносить на кожу поврежденную грибком.
При появлении дискомфорта или болевых ощущений необходимо прекратить процедуру. Причиной тому может быть чрезмерная концентрация средства или непереносимость какого-либо из препаратов.
Профилактика
Чем эффективно лечить грибок ногтей на ногах, лучше изначально не допустить заражения. Чтобы избавиться от неприятного заболевания, нужно придерживаться рекомендаций:
- не ходить босым в общественных местах;
- во время посещения спортзала, бассейна, аквапарка носить резиновые тапочки;
- использовать противогрибковый лак «Лоцерил», оказывающий фунгицидное действие;
- покупать удобные виды обуви из ткани или кожи;
- следить, чтобы в маникюрных салонах с вами работали только инструментами, прошедшими термическую обработку;
- не пользоваться тапочками, полотенцем или носками постороннего человека;
- не носить одниноски каждый день;
- мыть ноги утром и вечером;
- употреблять витамины, например, «Витрум» или «Перфектил»;
- при первых признаках грибкового заболевания использовать гель «Чистостоп–форте», избавляющий от зуда, шелушения и эрозии.
Йодная терапия
Использование спиртового раствора йода как антисептического средства – это, конечно же, медикаментозное лечение. Однако врач миколог назначит специальные антигрибковые препараты, соответствующие результатам лабораторного анализа соскоба ногтя. Йодная настойка – это самое доступное домашнее средство для борьбы с грибком на начальном этапе. Она помогает не при всех видах грибкового поражения.
Эту терапию целесообразно проводить в том случае, когда поражением затронуто не более трети ногтя. Лечебное действие заключается в способности спиртового раствора йода разрушать белок. Доказано, что грибок ногтя имеет белковую природу.
Людям, страдающим расстройством работы щитовидной железы и аллергией на йод, следует избегать такой терапии.
Отрицательным моментом использования йода является то, что ногти и кожа вокруг будут желтого цвета. Частое применение настойки может вызвать ожоги прилегающей кожи и дерматит. Достаточно капнуть на ногтевую пластину один раз в сутки одну каплю пяти- или десятипроцентного раствора йода в этиловом спирте. Пальцы, расположенные рядом, можно обработать для профилактики одной каплей раствора раз в 2 суток.
Йодную настойку можно применять в комплексной терапии с другими средствами:
- Йодная ванночка. Стопы парятся в горячей воде с добавлением небольшого количества йодной настойки. Температура должна быть такой, чтобы возможно было терпеть. Достаточно выдержать 10 минут. Распаренные ногтевые пластины нужно подстричь, максимально удаляя пораженные сегменты. После этого ногти обрабатываются перекисью водорода и смазываются антигрибковой мазью. Второй способ – обработать пальцы после обрезки ногтей смесью йода, чесночного сока, уксусной эссенции и антигрибкового препарата “Нитрофунгин” (все ингредиенты в равных частях по 1 ч. л.). Перед нанесением смесь тщательно взбалтывается. Ванночку можно делать ежедневно перед сном.
- Чередование йодной настойки, фукорцина и уксуса. Первые две недели смазывать пальцы фукорцином (препарат резорцинола, ацетона и борной кислоты), следующие две недели – настойкой йода, заключительные две недели – 9 % раствором уксуса.
- Содово-солевая ванночка. В литр разогретой воды насыпаются сода и морская соль (1 ст. л.+2 ст. л). Распаривание стоп проводится в течение получаса. Ногти обрезать, почистить пораженные фрагменты, отшлифовать пилкой. После обрезки пальцы помыть с мылом, посушить. Обмазать всю стопу йодной настойкой, включая ногтевые пластины и пространства между пальцами. После высыхания нанести второй слой, потом третий. Ванночки делать каждый вечер в течение месяца.
Если приведенные процедуры не окажут лечебного эффекта, то нужно сдать фрагмент ногтя на анализ и лечить по схеме, назначенной врачом-микологом или дерматологом.
Прочие средства
Чтобы вылечить грибок на ногах народными средствами, существует еще множество рецептов.

- Календула. Делают отвар, настаивают около 30 минут, смазывают ступни и ждут полного их высыхания. Курс лечения составляет 3−5 недель.
- Берёзовый дёготь. Ноги парят в мыльной воде, лишнюю кожу снимают пемзой, хорошо просушивают и мажут дёгтем поражённые места. Через 1,5 часа ноги вытирают, но не моют. Через два дня процедуру повторяют.
- Луковица. Очищенным и разрезанным пополам луком смазывают ступни или измельчают его в блендере и наносят в виде компрессов.
- Травы. В чистые носки кладут по горсти сухой травы ромашки, чистотела, мяты, крапивы, шалфея. Летом можно использовать свежие травы.
- Чайный гриб неделю настаивают в растворе сахара и обрабатывают повреждённые участки. А также можно лечить микоз по следующему рецепту: небольшой кусочек гриба освобождают от плёнок и измельчают. Полученную кашицу втирают в инфицированные участки. Повторяют 3 раза в день до полного излечивания.
- Махорка быстро и эффективно поможет справиться с микозом. Для этого в литре кипятка заваривают 1 ст. ложку махорки и кипятят в течение двух минут. Выливают в таз и парят ноги до остывания воды. После процедуры средство не смывают и не вытирают — ноги должны высохнуть самостоятельно. Для приготовления отвара можно выбрать ненужную в хозяйстве кастрюлю или другую ёмкость.
- Лист лопуха отбивают молотком с нижней стороны и прокатывают скалкой до выступления сока. Оборачивают листом ногу, бинтуют и надевают носок. Применяют на ночь.
- Спирт. Ватный тампон смачивают в спирте и закладывают между пальцами 1 раз в неделю. Курс лечения — 3 месяца.
- Салициловая мазь. В течение недели по утрам мажут ею ступни и надевают полиэтиленовый пакет и носки. Вечером повторяют манипуляции.
- Пищевая сода хорошо помогает избавиться от инфекции. Для процедуры готовят ванночку из 7 литров воды, в которую добавляют по три столовых ложки соды и натёртого хозяйственного мыла. После полного растворения компонентов опускают в ёмкость ноги и держат 20 минут. Повторяют в течение четырёх дней. Рекомендуется сочетать процедуру в комплексе с медикаментозным лечением.
- Борная кислота. На ночь ноги распаривают, но не вытирают насухо, а еще влажные припудривают порошком борной кислоты, затем надевают носки и оставляют до утра.
- Марганцовка. Перед сном ноги распаривают и обматывают марлей, смоченной в растворе марганцовки.
- Кофе. Ванночки на ночь готовят на основе крепкого натурального кофе. Дополнительно они сделают кожу мягкой.
- Горячая вода. Этим методом можно вылечить грибок между пальцами ног всего за 2−3 процедуры. Для этого включают горячую воду, которую едва терпят руки. Стоя в ванной, под струю воды 5−10 раз на несколько секунд заносят ногу с растопыренными пальцами. Ноги обсушивают полотенцем и опрыскивают больные места 6%-м уксусом.
- Мята. Измельчённую траву смешивают с солью и закладывают между пальцами на 60 минут.
- Свежесобранные листья рябины разминают и прикладывают к поражённым местам, фиксируют бинтом. Повязку рекомендуется держать круглосуточно.
- Нашатырный спирт. На 200 мл воды добавляют столовую ложку нашатырного спирта. Смачивают в растворе марлю, обёртывают стопу и сверху надевают полиэтиленовый пакет. Делают перед сном.
- Картофельные проростки измельчают и заливают спиртом, настаивают, а из получившейся кашицы делают компрессы.
- Яблочный уксус. Это народное средство от грибка стоп применяют только на ранней стадии микоза. Ватные диски смачивают уксусом и прикладывают к поражённым местам на 8−10 часов. Манипуляции проводят до исчезновения признаков заболевания с еженедельным перерывом на 2 дня.
- Клей БФ. Довольно смелый способ. Нужно смазывать клеем повреждённые участки кожи один раз в день на протяжении недели.
- Фракция АСД-2. Предварительно вымытые с мылом пораженные участки смазывают неразбавленным раствором 2−3 раза в день.

Подготовка ногтей перед нанесением уксуса
Яблочный уксус для ступни и для ног от грибка следует использовать правильно. Лечебные средства от грибка ног с яблочным уксусом применяются для лечения и профилактики. Чтобы средство быстро подействовало, необходимо предварительно подготовить ногтевые пластины к лечебной процедуре.
В первую очередь, ноги необходимо распарить. Для этого нужно приготовить специальную ванночку и опустить в нее ступни на 20 минут. При этом в качестве ванночки также можно использовать раствор яблочного уксуса.
После ванночки ноги тщательно моют хозяйственным или дегтярным мылом и вытирают насухо. Затем проводится обработка ногтевых пластин маникюрными инструментами. Отросшие частички ногтя необходимо срезать, ногтевые пластины нужно подпилить и отшлифовать специальным бруском. Это убирает все неровности, которые в противном случае мешали бы проникновению лечебного средства вглубь ногтевой пластины.
Яблочный уксус можно применять для лечения онихомикоза и грибка на коже стоп и пяток.
После подготовки на ногти наносится яблочный уксус. Это может быть компресс, примочка собственного приготовления или комбинация с другими средством. В случае запущенного грибка, после использования уксуса необходимо нанести специальный крем или лак.
Лечение грибка яблочным уксусом как самостоятельным средством эффективно только на начальной стадии заболевания. Характерные симптомы легкой формы грибка на ногтях:
- утолщение ногтевой пластины;
- изменение цвета или появление пятен;
- ломкость и хрупкость ногтей.
Если ногти сильно деформируются, а под ногтевыми пластинами собирается густое отделяемое с неприятным запахом – это запущенная форма болезни. В этом случае яблочный уксус должен применяться в дополнение к медикаментозному лечению, так как самостоятельное средство он не будет эффективен.
Как лечить грибок стопы народными средствами
Препараты домашнего приготовления выгодно отличаются от аптечных тем, что рецептура их проста и не требует больших затрат. Народные средства широко применяются в формах:
- ножных ванночек;
- компрессов;
- мазей;
- настоев, отваров лекарственных трав.
Избавиться от грибка можно, применяя березовый деготь. Это универсальное средство, которым лечат стопы, трещины, поражения между пальцами, больные ногти. Проблемные места смазывают тонким слоем препарата, а через 1,5 часа снимают салфеткой. Обмывать ноги нельзя 2 суток. Процедуру повторяют 3-5 раз, пока средство не окажет нужное действие. Еще популярны:
- Столовый уксус (не путать с эссенцией, которой можно сжечь ноги). Грибок не переносит кислую среду. Регулярные уксусные ванночки постепенно уничтожают инфекцию.
- Чеснок. Его растирают пополам со сливочным маслом и наносят в виде компрессов на ночь.
- Лук. Это совсем простое решение: луковицу разрезают и соком натирают проблемные места.

Средство против грибка на ногах между пальцами
Многим помогают такие рецепты:
- Листья мяты размять, чтобы выделился сок, посолить и смазать кашицей межпальцевые промежутки. Через 1 час смыть.
- Проростки клубней картофеля измельчить, залить доверху спиртом, настаивать 3-4 дня. Делать компрессы на ночь.
- Припудривать влажные после распаривания ноги борной кислотой, густо засыпая порошок между больными пальцами.
Лечение грибка кожи на ногах
Это тоже несложные рецепты. Оздоровить кожу помогают такие народные средства от грибка на ногах:
- Кора дуба. Делать ножные ванночки с теплым отваром.
- Лимон. Смазывать соком больную кожу. Можно чередовать с соком лука.
- Кофе. Это быстрое средство от грибка кожи на ногах. Заварить крепкий напиток и делать ножные ванночки.

Лекарства от грибка стопы на подошве
Если размножение идет на подошве, есть несколько вариантов лечения:
- Когда болезнь только началась, можно испробовать растворимый кофе. В носки каждый день подсыпают свежий порошок и ходят примерно неделю.
- Востребованное народное средство от грибка на ногах – 9% столовый уксус. Подошвы многократно смазывают им в течение полумесяца.
- Отличный метод лечения – аппликации с пихтовым маслом, это замечательный антисептик.
Народные средства от грибка на ногтях
Самый популярный и эффективный рецепт – куриное яйцо, растворенное в уксусной эссенции (не больше полстакана). После недельного настаивания в темноте – пока скорлупа не растворится – массу взбивают со 100 г сливочного масла. Этой мазью ежевечерне смазывают распаренные ногти. Пораженные пластинки становятся мягкими, и их срезают. Процедуры чередуют с содово-мыльными ванночками. Кроме того, ногти смазывают:
- настойкой прополиса;
- соком чеснока;
- отваром коры дуба.
Узнайте, как выбрать противогрибковое средство в таблетках.
Березовый деготь и хозяйственное мыло при микозе
При поражении ногтей грибком возьмите хозяйственное мыло и мочалкой растирайте им ноги или руки в теплой воде. После этого на протяжении 15-20 минут конечности нужно распаривать в этой мыльной воде. Когда ноги распарятся, почистите подошвы ступней пемзой, чтобы удалить загрубевшую кожу
После такой процедуры не забудьте насухо вытереть ноги, уделяя внимание, прежде всего, областям между пальцев
Теперь можно использовать березовый деготь. Намажьте им ногти, области между пальцами и трещинки на пальцах. Обработанные дегтем конечности поместите на газету и посидите так 1,5 часа. Насухо оботрите их, наденьте хлопковые носки и не снимайте их двое суток. Спустя 2 дня носки можно будет снять и вымыть ноги водным раствором с добавлением хозяйственного мыла.
Через неделю процедуру повторяют. Если все делать правильно, всего 2 такие процедуры, а также комплексное лечение медикаментозными средствами помогут вам избавиться от такого неприятного заболевания, как микоз.




























